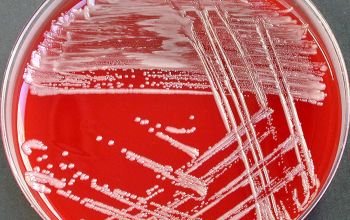

Oligella urethralis
-
General information
Taxonomy
Family: Alcaligenaceae
Formerly Moraxella urethralis
Natural habitat
Unknown, can colonize the distal (bottom section) of the urethra
O. urethralis is commensal in the urogenitaliën
Clinical significance
Transmission through manipulation of catheters.
These microorganisms are usually isolated from the urinary tract and also known as cause of urosepsis.
-
Gram stain
Small, paired, gram-negative coccoid rods
and often occurs in pairs
-
Culture characteristics
-
Obligate Aerobic
BA: colonies develop slowly and are small, opaque, white and non-hemolytic.
McConkey: growth non lactose fermenter
BBAØ: no growth
-
-
Characteristics
-
References
James Versalovic et al.(2011) Manual of Clinical Microbiology 10th Edition
Karen C. Carrol et al (2019) Manual of Clinical Microbiology, 12th Edition